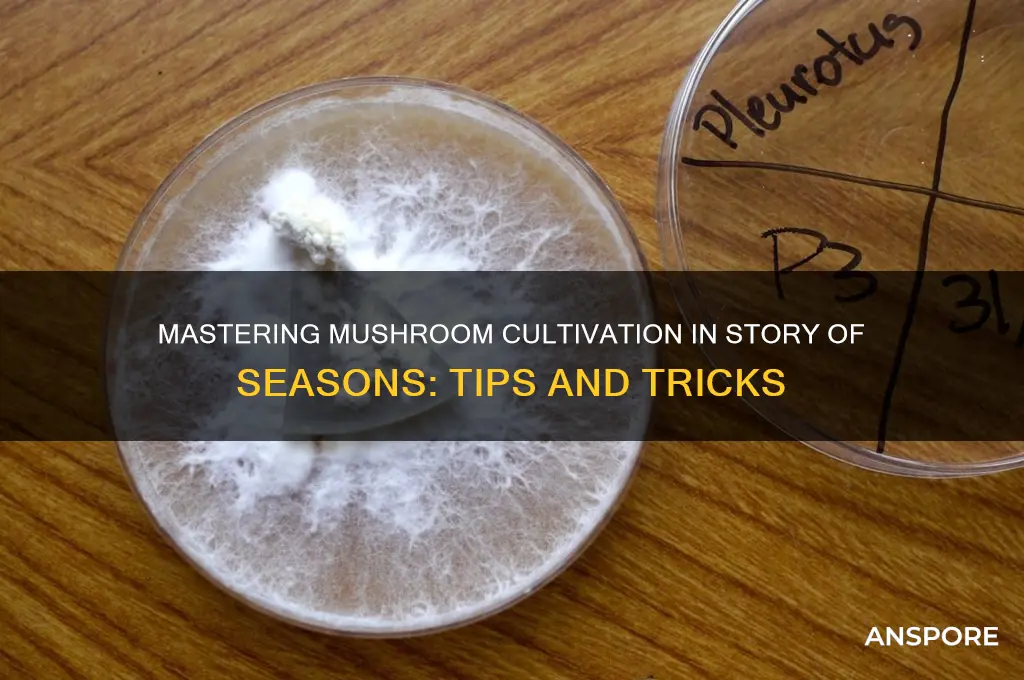
how to grow mushrooms story of seasons

Growing mushrooms in *Story of Seasons* is a rewarding and engaging activity that adds depth to your farming experience. In the game, players can cultivate various types of mushrooms, such as shiitake and tree mushrooms, by creating the ideal environment in their farm's cave or grove. To start, you’ll need to gather materials like hardwood logs or stumps, which serve as the substrate for mushroom growth. Once placed in a damp, shaded area, these logs will eventually spawn mushrooms that can be harvested and sold for profit or used in recipes. Proper care, including regular watering and maintaining the right conditions, is essential for maximizing yields. As you progress, unlocking new mushroom varieties and optimizing their growth becomes a satisfying challenge, blending resource management with the game’s charming farming mechanics.
| Characteristics | Values |
|---|---|
| Game | Story of Seasons (Series) |
| Mushroom Types | Various (e.g., Common Mushroom, Truffle, Glow Mushroom) |
| Growing Location | Cave, Greenhouse, or Specific In-Game Areas |
| Required Tools | Hoe, Watering Can, and sometimes a Pickaxe |
| Soil Preparation | Till the soil in designated areas |
| Seeding | Plant mushroom spores or seeds obtained from shops or foraging |
| Watering | Daily watering is required until fully grown |
| Growth Time | Varies by type (e.g., 5-10 days for Common Mushrooms) |
| Harvesting | Use a tool or hands to harvest when fully grown |
| Seasons | Can be grown year-round in caves or greenhouses; seasonal restrictions may apply outdoors |
| Profitability | High-value crops like Truffles yield significant profits |
| Additional Tips | Maintain proper humidity, avoid overwatering, and keep the area clean |
| Game Versions | Mechanics may vary slightly across different Story of Seasons titles |
Explore related products
What You'll Learn
- Choosing Mushroom Types: Select varieties like shiitake, oyster, or lion’s mane suited for your climate and soil
- Preparing the Substrate: Use straw, wood chips, or sawdust, sterilize, and inoculate with mushroom spawn
- Optimal Growing Conditions: Maintain humidity (70-90%), temperature (55-75°F), and indirect light for healthy growth
- Harvesting Techniques: Pick mushrooms at the right stage to ensure continued fruiting and avoid spoilage
- Troubleshooting Common Issues: Address mold, pests, or slow growth with proper ventilation and substrate care

Choosing Mushroom Types: Select varieties like shiitake, oyster, or lion’s mane suited for your climate and soil
When choosing mushroom types for your Story of Seasons farm, it's essential to consider varieties that thrive in your specific climate and soil conditions. Shiitake, oyster, and lion's mane mushrooms are popular choices, each with unique requirements and benefits. Shiitake mushrooms, for instance, prefer a cooler environment and grow well in hardwood logs or sawdust-based substrates. They are a great option if you have access to oak, maple, or beech trees, as these woods provide the ideal growing medium. Oyster mushrooms, on the other hand, are more versatile and can grow in a variety of substrates, including straw, coffee grounds, and even cardboard. They are well-suited for warmer climates and can be cultivated indoors or outdoors, making them an excellent choice for beginners.
Lion's mane mushrooms are another excellent option, particularly if you're looking for a unique, medicinal variety. They prefer cooler temperatures and grow well in sawdust or wood chip-based substrates. When selecting lion's mane, consider your climate and ensure you can provide the necessary conditions, such as a shaded area with good air circulation. It's also crucial to research the specific temperature and humidity requirements for each mushroom type, as these factors can significantly impact their growth and yield. For example, shiitake mushrooms typically require temperatures between 55-75°F (13-24°C), while oyster mushrooms can tolerate a wider range of 50-80°F (10-27°C).
In addition to climate considerations, soil quality plays a vital role in mushroom cultivation. While mushrooms don't directly absorb nutrients from the soil like plants do, the substrate you use should be rich in organic matter and have good water retention properties. For outdoor beds, ensure your soil is well-draining and amended with compost or aged manure to create a nutrient-rich environment. If you're using hardwood logs or straw, make sure they are free from contaminants and properly pasteurized or sterilized to prevent competing fungi and bacteria from affecting your crop.
When deciding between shiitake, oyster, or lion's mane mushrooms, think about your farming goals and the resources available to you. Shiitake mushrooms are a premium variety, often commanding higher prices at market, but they require more specific growing conditions and a longer incubation period. Oyster mushrooms, with their rapid growth and high yield, are an excellent choice for commercial production or for those looking to generate a steady income. Lion's mane mushrooms, while more niche, offer unique health benefits and can be a lucrative specialty crop for farmers willing to cater to the growing demand for medicinal mushrooms.
Ultimately, the key to successful mushroom cultivation in Story of Seasons is to match the right variety with your specific conditions. Consider starting with a variety that is well-suited to your climate and soil, and gradually experiment with other types as you gain experience. Remember to monitor temperature, humidity, and substrate quality throughout the growing process, making adjustments as needed to ensure a healthy and productive crop. By carefully selecting mushroom types and providing optimal growing conditions, you'll be well on your way to a thriving mushroom farm in your Story of Seasons game.
Can Psychedelic Mushrooms Thrive in December's Cold Climate?
You may want to see also

Preparing the Substrate: Use straw, wood chips, or sawdust, sterilize, and inoculate with mushroom spawn
Growing mushrooms in *Story of Seasons* requires careful preparation of the substrate, which serves as the foundation for healthy mushroom growth. The first step is selecting the right material for your substrate. Straw, wood chips, or sawdust are excellent choices due to their ability to retain moisture and provide nutrients for the mushrooms. Straw is particularly popular for beginners because it is easy to handle and widely available. Wood chips and sawdust, on the other hand, are denser and may require more attention to moisture levels but can support a wider variety of mushroom species. Once you’ve chosen your material, ensure it is clean and free from contaminants that could hinder mushroom growth.
After selecting your substrate, the next critical step is sterilization. Sterilizing the substrate eliminates any competing bacteria, fungi, or pests that could interfere with the mushroom spawn. To sterilize straw, soak it in hot water (around 180°F or 82°C) for about an hour, then drain and cool it. For wood chips or sawdust, steaming or pressure cooking is more effective. If using a pressure cooker, cook the substrate at 15 psi for 1.5 to 2 hours. Allow the substrate to cool to a temperature that is safe to handle, typically around 75–80°F (24–27°C), before proceeding to the next step. Proper sterilization ensures that the mushroom spawn has the best chance to colonize the substrate without competition.
Once the substrate is sterilized and cooled, it’s time to inoculate it with mushroom spawn. Mushroom spawn is essentially the "seed" of the mushroom, consisting of mycelium grown on a medium like grain. Mix the spawn thoroughly into the substrate, ensuring even distribution. For every 5 pounds of straw, use 1 pound of spawn, and adjust the ratio accordingly for wood chips or sawdust. This step requires a clean environment to prevent contamination, so work in a space with minimal dust or debris, and consider using gloves and a mask. Proper inoculation is crucial for the mycelium to spread effectively throughout the substrate.
After inoculation, the substrate needs to be placed in a suitable environment for the mycelium to colonize. Transfer the mixture into a growing container, such as a plastic bag or tray with small holes for ventilation. Seal the bag or cover the tray to maintain humidity, but ensure there is enough airflow to prevent the buildup of carbon dioxide. Keep the substrate in a dark, cool area with temperatures between 60–75°F (15–24°C), depending on the mushroom species. Colonization can take 2–4 weeks, during which the mycelium will grow and prepare the substrate for fruiting. Patience is key during this phase, as rushing the process can lead to poor results.
Finally, monitor the substrate regularly for signs of contamination or uneven colonization. If mold appears, it may indicate that the substrate was not properly sterilized or that contamination occurred during inoculation. In such cases, remove the affected areas immediately to prevent further spread. Once the substrate is fully colonized, it’s ready for the fruiting stage, where mushrooms will begin to grow. By carefully preparing the substrate—using the right materials, sterilizing effectively, and inoculating properly—you set the stage for a successful mushroom harvest in *Story of Seasons*.
Growing Mushrooms in India: A Step-by-Step Farming Guide
You may want to see also

Optimal Growing Conditions: Maintain humidity (70-90%), temperature (55-75°F), and indirect light for healthy growth
Growing mushrooms in *Story of Seasons* requires a keen understanding of their optimal environmental needs. Humidity is a critical factor, as mushrooms thrive in conditions with 70-90% humidity. To achieve this, ensure your mushroom beds are placed in a well-ventilated area but not exposed to direct drafts. Using a humidifier or regularly misting the area can help maintain the necessary moisture levels. Avoid over-saturating the substrate, as excessive water can lead to mold or root rot, which will harm your mushroom crop.
Temperature plays an equally vital role in mushroom cultivation, with the ideal range being 55-75°F (13-24°C). Mushrooms are sensitive to extreme temperatures, so avoid placing them near heat sources or in areas prone to cold drafts. In *Story of Seasons*, monitor the in-game weather and seasonal changes to ensure your mushrooms are not exposed to temperatures outside this range. If the temperature drops too low, consider using a small heater or moving the mushroom beds to a warmer location. Conversely, during hotter periods, provide shade or use cooling methods to keep the temperature stable.
Indirect light is another essential condition for healthy mushroom growth. Unlike many plants, mushrooms do not require direct sunlight, as it can dry out their environment and hinder development. Instead, place your mushroom beds in a shaded area with diffused, natural light. In *Story of Seasons*, this could mean positioning them under trees, near walls, or in a greenhouse with shaded windows. Ensure the area is not completely dark, as some light is still necessary for the mushrooms to photosynthesize and grow properly.
Maintaining these optimal growing conditions requires consistent monitoring and adjustments. Regularly check the humidity levels using a hygrometer and adjust misting or humidifier settings accordingly. Keep an eye on the in-game thermometer to ensure the temperature remains within the ideal range. Additionally, periodically inspect the mushroom beds to ensure they are receiving adequate indirect light and are not being overshadowed by other crops or structures. By diligently managing these factors, you’ll create an environment where your mushrooms can flourish in *Story of Seasons*.
Finally, patience is key when growing mushrooms. Unlike faster-growing crops, mushrooms take time to develop, and their growth is heavily dependent on the stability of their environment. Avoid making drastic changes to their conditions, as this can stress the mushrooms and stunt their growth. Instead, focus on gradual adjustments and consistent care. With the right humidity, temperature, and light, you’ll soon see healthy, robust mushrooms ready for harvest, contributing to the success of your farm in *Story of Seasons*.
Mastering King Oyster Mushroom Cultivation: A Beginner's Home-Growing Guide
You may want to see also
Explore related products

Harvesting Techniques: Pick mushrooms at the right stage to ensure continued fruiting and avoid spoilage
In the world of *Story of Seasons*, growing mushrooms is a rewarding endeavor, but harvesting them at the right stage is crucial to ensure continued fruiting and prevent spoilage. Mushrooms typically take about 7 to 10 days to mature after the mycelium has fully colonized the substrate. The ideal time to harvest is when the caps are fully open but the gills are still slightly closed. At this stage, the mushrooms are at their peak flavor and texture, and harvesting them encourages the mycelium to produce more fruiting bodies. Avoid waiting until the caps flatten or the gills darken, as this indicates overmaturity, which can lead to spore release and reduced yields.
To harvest mushrooms properly, use a sharp knife or your fingers to gently twist and pull the mushroom from the substrate. Be careful not to damage the surrounding mycelium or other developing mushrooms. Harvesting should be done daily once the first mushrooms appear, as leaving mature mushrooms in the substrate can signal to the mycelium that it’s time to stop producing. Regular harvesting also prevents overcrowding, which can lead to mold or other contaminants. Always inspect your mushroom bed daily to catch them at the optimal stage.
After harvesting, it’s essential to handle the mushrooms carefully to avoid spoilage. Clean them gently with a soft brush or damp cloth to remove any substrate debris, but avoid washing them thoroughly, as excess moisture can cause them to deteriorate quickly. Store harvested mushrooms in a breathable container, like a paper bag or a loosely closed container, in a cool, dry place. Proper storage extends their freshness, allowing you to enjoy your harvest or sell them at the highest price in the game.
Another key aspect of harvesting techniques is maintaining the health of the mycelium for continued fruiting. After each harvest, ensure the growing environment remains optimal—keep the humidity around 85-95% and maintain a consistent temperature of 60-70°F (15-21°C). Mist the substrate lightly if it begins to dry out, but avoid overwatering, as this can lead to mold or rot. By creating a stable environment and harvesting at the right stage, you encourage the mycelium to produce multiple flushes of mushrooms, maximizing your yield in *Story of Seasons*.
Lastly, pay attention to the signs of aging in your mushroom bed. If you notice the mycelium turning yellow or the substrate drying out despite proper care, it may be time to replace the bed. However, with proper harvesting techniques and environmental management, a single mushroom bed can produce for several weeks. By mastering the art of harvesting at the right stage, you’ll not only enjoy a steady supply of mushrooms but also contribute to the overall success of your farm in the game.
How Mushrooms Nourish Themselves: Unveiling the Mycelium Network
You may want to see also

Troubleshooting Common Issues: Address mold, pests, or slow growth with proper ventilation and substrate care
Growing mushrooms in *Story of Seasons* can be a rewarding endeavor, but it’s not without its challenges. Common issues like mold, pests, and slow growth can hinder your success, but with proper ventilation and substrate care, these problems can be effectively addressed. Let’s dive into troubleshooting these issues step by step.
Addressing Mold Growth
Mold is a frequent issue when growing mushrooms, often arising from excessive moisture or poor air circulation. To combat mold, ensure your mushroom beds have adequate ventilation. In *Story of Seasons*, placing your mushroom logs or beds in a well-ventilated area, such as near an open window or in a shed with airflow, can prevent stagnant air. Additionally, avoid overwatering the substrate. Mushrooms thrive in a humid environment, but too much moisture encourages mold. Use a spray bottle to mist the area lightly instead of pouring water directly onto the substrate. If mold appears, carefully remove the affected areas with a clean tool to prevent it from spreading.
Managing Pests
Pests like flies or mites can infest your mushroom beds, damaging the mycelium and reducing yield. To deter pests, maintain a clean growing environment. Regularly inspect your mushroom beds for signs of infestation, such as tiny holes or webbing. Introducing natural predators, like ladybugs, can help control pest populations. In *Story of Seasons*, ensure your farm is free of debris and other attractants that might draw pests. If an infestation occurs, isolate the affected beds and treat them with organic pest control methods, such as neem oil or diatomaceous earth, to protect your mushrooms without harming the ecosystem.
Solving Slow Growth
Slow growth is often a sign of improper substrate care or inadequate environmental conditions. Mushrooms require a nutrient-rich substrate, so ensure you’re using high-quality materials like straw, wood chips, or compost. In *Story of Seasons*, regularly check the moisture level of your substrate; it should feel like a wrung-out sponge. If the substrate is too dry, growth will stall, so mist it lightly to maintain humidity. Temperature also plays a crucial role—most mushrooms grow best between 60°F and 75°F (15°C and 24°C). If your growing area is too cold or too hot, consider moving the beds to a more suitable location or using insulation to regulate temperature.
Maintaining Proper Ventilation
Proper ventilation is key to preventing many mushroom-growing issues. Stagnant air can lead to mold, slow growth, and even pest infestations. In *Story of Seasons*, avoid overcrowding your mushroom beds, as this restricts airflow. Space them adequately and ensure the growing area isn’t enclosed. If growing indoors, use fans to promote air circulation without creating drafts that could dry out the substrate. Regularly turn or fluff the substrate to introduce fresh air and prevent compaction, which can suffocate the mycelium.
Caring for the Substrate
The substrate is the foundation of your mushroom garden, and its health directly impacts your harvest. In *Story of Seasons*, pasteurize your substrate before use to kill harmful bacteria and pests. This can be done by soaking it in hot water or steaming it. Once your mushrooms are growing, monitor the substrate’s pH level, which should ideally be between 5.5 and 6.5. If the substrate becomes contaminated or depleted, replace it to ensure continuous growth. Regularly inspect the substrate for signs of decay or infestation, and address issues promptly to maintain a thriving mushroom garden.
By focusing on proper ventilation and substrate care, you can troubleshoot common issues like mold, pests, and slow growth in *Story of Seasons*. With patience and attention to detail, you’ll soon enjoy a bountiful harvest of delicious, homegrown mushrooms.
Mastering Mushroom Mic Cultivation: A Step-by-Step Growing Guide
You may want to see also
Frequently asked questions
To grow mushrooms, you need a Mushroom Log, which can be purchased from the Carpenter or found in the forest. Place the log in a shaded area, such as under trees or in a cave, and keep the soil moist by watering it regularly.
Mushrooms typically take 7 days to grow after placing the Mushroom Log. Ensure the log remains watered and in a shaded spot for successful growth.
Yes, mushrooms can be grown year-round as long as the Mushroom Log is placed in a shaded area and kept watered. They are not affected by seasonal changes.
The Mushroom Log produces regular Mushrooms, which can be harvested and used for cooking, selling, or gifting. There are no variations in mushroom types from the log.











































